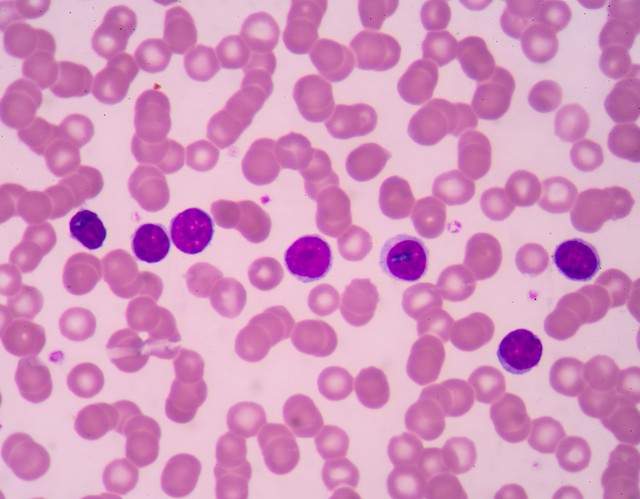

B 细胞在人体免疫系统中扮演着至关重要的角色,其表达特异性抗体的能力是一个复杂而精妙的过程,涉及到先天和后天因素的共同作用。

从先天层面来看,B 细胞在个体发育过程中就具备了一定的基础能力。人体的基因组中蕴含了编码 B 细胞相关受体和分子的基因,这些基因在胚胎发育阶段就开始表达,为 B 细胞的初始发育和基本功能奠定了基础。例如,B 细胞表面的一些先天性受体能够识别广泛存在的病原体相关分子模式,这使得 B 细胞在生命初期就具备了对一些常见病原体的初步识别能力,这种能力可以看作是一种先天的防御机制。它为 B 细胞后续的活化和特异性免疫反应提供了一个起始的平台,类似于为免疫系统建造了一座坚固的基石。
然而,后天因素在 B 细胞表达特异性抗体的能力塑造中起着更为关键的作用。当个体接触到外界环境中的病原体后,B 细胞会被激活并启动一系列复杂的免疫反应过程。抗原的刺激是其中的核心环节,不同的抗原具有独特的结构和化学性质。B 细胞通过其表面的抗原受体(BCR)特异性识别抗原,这种识别引发了细胞内的信号传导,促使 B 细胞进行增殖和分化。在这个过程中,B 细胞会经历体细胞高频突变和抗体类别转换等重要事件。体细胞高频突变使得 B 细胞的抗体基因发生突变,从而产生具有不同亲和力的抗体,经过筛选,那些能够更好地结合抗原的 B 细胞得以存活和进一步扩增,这大大提高了抗体的特异性和亲和力。抗体类别转换则使 B 细胞能够根据不同的免疫需求,产生不同类型的抗体,如 IgM 转换为 IgG、IgA 等,以更好地发挥免疫功能。此外,后天的免疫记忆也是 B 细胞表达特异性抗体能力的重要体现。当再次遇到相同抗原时,记忆 B 细胞能够迅速活化并产生大量高亲和力的特异性抗体,实现快速而有效的免疫应答,这是免疫系统在后天环境中不断学习和适应的结果。

综上所述,B 细胞表达特异性抗体的能力并非单纯由先天或后天因素决定,而是先天基础与后天环境相互作用、相互影响的结果。先天因素为 B 细胞提供了基本的框架和潜在的能力,而后天因素则如同精细的雕刻师,通过抗原刺激、细胞分化和免疫记忆等过程,不断塑造和完善 B 细胞表达特异性抗体的能力,使免疫系统能够更加精准、有效地应对外界病原体的挑战,保障人体的健康。这种先天与后天的完美结合,体现了生命系统在进化过程中形成的精妙适应性和防御机制。
全部评论(0条)
 EBV转化淋巴细胞系带绿色荧光;Akata/GFP
EBV转化淋巴细胞系带绿色荧光;Akata/GFP
报价:面议 已咨询 53次
 EBV转化淋巴细胞系;Akata
EBV转化淋巴细胞系;Akata
报价:面议 已咨询 28次
 EB病毒感染的人外周淋巴细胞;JVM-2
EB病毒感染的人外周淋巴细胞;JVM-2
报价:面议 已咨询 19次
 Expi293F (STR)
Expi293F (STR)
报价:面议 已咨询 17次
 PC-9GR(PC-9吉非替尼耐药) (STR)
PC-9GR(PC-9吉非替尼耐药) (STR)
报价:面议 已咨询 11次
 SV-40转化肺成纤维细胞;WI38/VA13 (STR)
SV-40转化肺成纤维细胞;WI38/VA13 (STR)
报价:面议 已咨询 11次
 SV40T转化的人胚肾细胞; 293T (STR)
SV40T转化的人胚肾细胞; 293T (STR)
报价:面议 已咨询 20次
 SV40T转化人脐静脉内皮细胞;PUMC-HUVEC-T1 (STR)
SV40T转化人脐静脉内皮细胞;PUMC-HUVEC-T1 (STR)
报价:面议 已咨询 16次
2022-12-08
 单B细胞抗体技术的关键步骤
单B细胞抗体技术的关键步骤
2022-08-24
 上海富衡 | B 细胞表达特异性抗体的能力
上海富衡 | B 细胞表达特异性抗体的能力
2024-10-27
 上海富衡 | B 细胞活化因子受体相关药物的解析
上海富衡 | B 细胞活化因子受体相关药物的解析
2024-10-11
2025-08-13
2020-09-14













①本文由仪器网入驻的作者或注册的会员撰写并发布,观点仅代表作者本人,不代表仪器网立场。若内容侵犯到您的合法权益,请及时告诉,我们立即通知作者,并马上删除。
②凡本网注明"来源:仪器网"的所有作品,版权均属于仪器网,转载时须经本网同意,并请注明仪器网(www.yiqi.com)。
③本网转载并注明来源的作品,目的在于传递更多信息,并不代表本网赞同其观点或证实其内容的真实性,不承担此类作品侵权行为的直接责任及连带责任。其他媒体、网站或个人从本网转载时,必须保留本网注明的作品来源,并自负版权等法律责任。
④若本站内容侵犯到您的合法权益,请及时告诉,我们马上修改或删除。邮箱:hezou_yiqi
参与评论
登录后参与评论